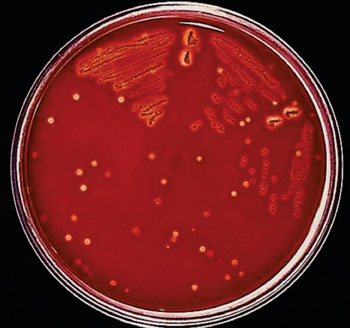
图片：A组链球菌属接种的胰酶大豆琼脂（含5%的去纤维蛋白羊血）平皿（照片由Richard R. Facklam博士提供）。

基于DNA的分析检测A组链球菌属
By LabMedica International staff writers
Posted on 01 Dec 2016
作为一种独有的人类病原体,A组链球菌属(GAS;酿脓链球菌)在社区中通过人与人之间直接传播,GAS还能在健康的宿主身体里寄居,这些宿主没有明显的临床体征或症状。Posted on 01 Dec 2016
在临床微生物学中,将标准培养法视为微生物检测的“金标准”,因为临床分离物的表型特征对于确定治疗方向是很重要的,但此类方法费用昂贵且耗时。
图片:A组链球菌属接种的胰酶大豆琼脂(含5%的去纤维蛋白羊血)平皿(照片由Richard R. Facklam博士提供)。
这两种方法,培养物相关法和无关法,用于检测健康成人咽喉拭子中的GAS。培养物相关法中,将拭子涂在两种类型的琼脂培养基上,并额外将拭子浸入培养基;将每个咽喉拭子浸入胰蛋白酶大豆肉汤(TSB)中,并加入1.2毫升的新配TSB进行富集。培养物无关研究中,使用聚合酶链式反应(PCR)扩增提取的DNA,使用两个GAS特定引物对:一个为新指定的16S rRNA特定引物对,另一个是此前所述的V-Na+-ATP酶引物对。使用M13引物和3130基因分析仪(Applied Biosystems,Foster City CA,USA)对克隆的PCR产物进行测序。
科学家发现,使用培养物相关方法仅发现148份样品中的5份(3.4%)样品是GAS阳性,但使用培养物无关法发现146份(98.6%)样品GAS DNA阳性。为了使用M型蛋白基因(emm)分型获得血清型信息,他们使用新指定的emm引物进行套式PCR。他们从25份(16.9%)样品中检测出了四种不同的emm型,这些分型不同于日本GAS疾病相关的常见emm型。从健康志愿者中检测到的不同emm型指示,出现独有的emm型可能与GAS携带者相关。
作者们得出结论,培养物无关法将被视为健康宿主的GAS属性分析法,以便更好地了解这些微生物。本研究中使用的GAS专属引物(16S rRNA和V-Na+-ATP酶)能用于评估人群中最有可能的GAS携带情况。这些结果提示,不仅是学龄儿童,就是健康成人也可能是GAS携带者。本研究已发表于2016年10月11日刊的BMC Microbiology(BMC微生物学)杂志。
Related Links:
Tokyo Medical and Dental University
MO BIO Laboratories
Applied Biosystems







